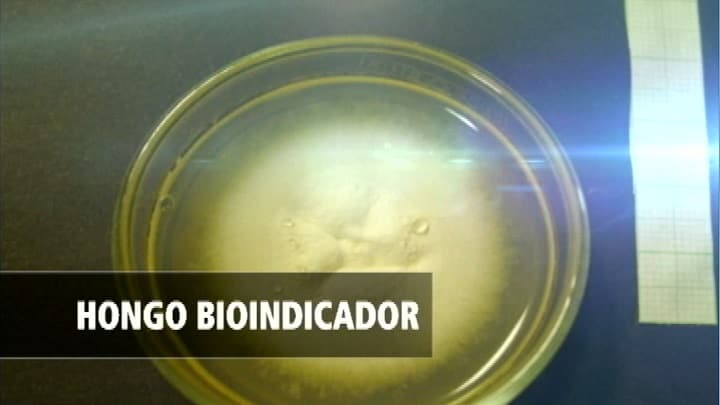

Actualidad
Importante especie de hongo fue descubierta en Colombia
Durante los últimos meses se han reportado altos índices de contaminación en calidad del aire de Bogotá.
El descubrimiento de una nueva especie de hongo, que por sus características naturales se comporta como bio-indicador en mediciones de la calidad del aire, hace parte de los importantes aportes científicos que ha hecho el grupo de investigación del Laboratorio de Micología y Fitopatología – LAMFU de la Universidad de los Andes, en Bogotá, Colombia.
Lo que más sorprende de esta especie de hongo es la capacidad de presentar cambios en sus características físicas al verse expuestos a altos índices de contaminación, un descubrimiento que revela la afectación que produce la contaminación del aire en la biodiversidad.
Redacción: CLÍ-MAX

































